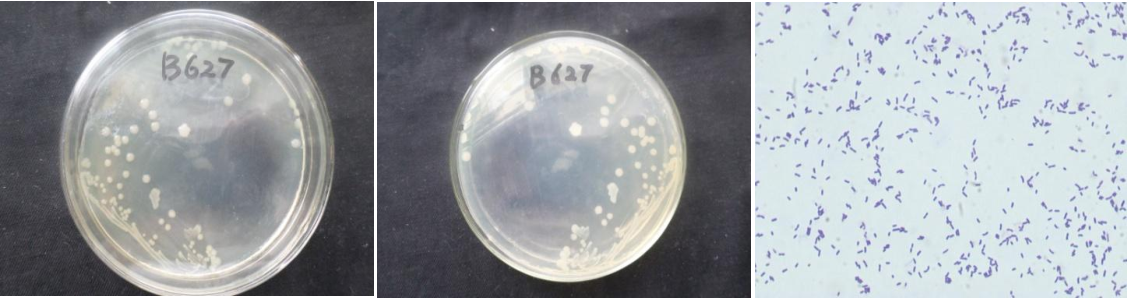

Loading...
| StrainNO | B627 |
| Classification | Pseudomonas |
| 16s rDNA sequence | CAACAGAAATGGCGGCGGCTACACATGCAAGTCGAGCGGCAGCACGGGTACTTGTACCTGGTGGCGAGCGGCGGACGGGT GAGTAATGCCTAGGAATCTGCCTAGTAGTGGGGGATAACGTCCGGAAACGGGCGCTAATACCGCATACGTCCTACGGGAG AAAGTGGGGGATCTTCGGACCTCACGCTATTAGATGAGCCTAGGTCGGATTAGCTAGTTGGTGAGGTAATGGCTCACCAA GGCTACGATCCGTAACTGGTCTGAGAGGATGATCAGTCACACTGGAACTGAGACACGGTCCAGACTCCTACGGGAGGCAG CAGTGGGGAATATTGGACAATGGGCGAAAGCCTGATCCAGCCATGCCGCGTGTGTGAAGAAGGTCTTCGGATTGTAAAGC ACTTTAAGTTGGGAGGAAGGGCAGTTACCTAATACGTGATTGTTTTGACGTTACCGACAGAATAAGCACCGGCTAACTCT GTGCCAGCAGCCGCGGTAATACAGAGGGTGCAAGCGTTAATCGGAATTACTGGGCGTAAAGCGCGCGTAGGTGGTTTGTT AAGTTGAATGTGAAAGCCCCGGGCTCAACCTGGGAACTGCATCCAAAACTGGCAAGCTAGAGTATGGTAGAGGGTGGTGG AATTTCCTGTGTAGCGGTGAAATGCGTAGATATAGGAAGGAACACCAGTGGCGAAGGCGACCACCTGGACTGATACTGAC ACTGAGGTGCGAAAGCGTGGGGAGCAAACAGGATTAGATACCCTGGTAGTCCACGCCGTAAACGATGTCAACTAGCCGTT GGGAGCCTTGAGCTCTTAGTGGCGCAGCTAACGCATTAAGTTGACCGCCTGGGGAGTACGGCCGCAAGGTTAAAACTCAA ATGAATTGACGGGGCCCGCACAAGCGGTGGAGCATGGTGGTTTATTCGAAGCAACGCGAAGAACCCTTACCAGGCCTTGA CATCCAATGAACTTTCTAGAGATAGATTGGTGCCTTCCGGGACATTGAGACAGGTGCTGCATGCTGTCGTCAGCCTCGTG TCTGGAAATGTGGGTAGTCCCGTTACGAGCGCACCTTGTCTTAGTACAGCACGTTATGGGTGGGCACCTCTAGGAACTGC GTGACAAATCGAGAGTGGATGACGTCAGTCATCAATGGCCTACGGCTGGCTTACACACGAGCTCTCATGTCGTCAAGGGT TCAGCTCGAAGGTGGAAACATATTCCTATAAAC |
| Strain Morphology Photos | |
| Morphological Description | Colony round;clam white;Spine-like margin;Concentric ring;middle convex;wrinkled;slippy;sticky;waxy;Bacteriophage Rod-shaped;no spore |